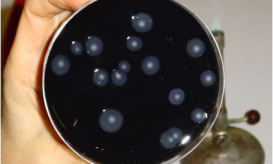

ΠΟΥ: Αυξάνονται κρούσματα και θάνατοι από τη μυστηριώδη νόσο στο Κονγκό
Οι Αρχές νόμιζαν ότι είναι σοβαρή μορφή ελονοσίας. Τι αναφέρει ο Παγκόσμιος Οργανισμός Υγείας.

Οι Αρχές νόμιζαν ότι είναι σοβαρή μορφή ελονοσίας. Τι αναφέρει ο Παγκόσμιος Οργανισμός Υγείας.

Πόσοι άνθρωποι έχουν αρρωστήσει έως τώρα. Οι νεότερες ανακοινώσεις του Υπουργείου Υγείας της χώρας.

Τα περίεργα συμπτώματα που προκαλεί, κυρίως σε γυναίκες και κορίτσια. Εκατοντάδες τα κρούσματα.

Εμπρός Έμπολα και πίσω… μαλάρια! Στην Γουϊνέα, στην προσπάθειά τους να αντιμετωπίσουν την «λαίλαπα» της επιδημίας του αιμορραγικού πυρετού...

Νέα έρευνα Δανών επιστημόνων υποστηρίζει ότι η νόσος του Πάρκινσον μπορεί να αρχίζει στο γαστρεντερικό σύστημα και να εξαπλώνεται...

Όταν τα χρόνια περνούν είναι φυσιολογικό οι άνθρωποι να ξεχνούν διάφορα γεγονότα αλλά και καταστάσεις. Υπολογίζεται ότι ένας στους οκτώ...

Η στεφανιαία νόσος είναι η νόσος των αγγείων της καρδιάς (στεφανιαία αγγεία) και μπορεί να προκαλέσει έμφραγμα. Διαβάστε στο...

Αποκαλείται «γρίπη των πτηνών» όμως όταν ο ιός Η5Ν1 που την προκαλεί περάσει στους ανθρώπους έχει ποσοστό θνησιμότητας 60%....

Νούμερο ένα πρόβλημα που αντιμετωπίζουν οι γυναίκες είναι οι διάφορες παθήσεις στην ευαίσθητη περιοχή. Μια από αυτές είναι η...

Η νόσος Αδαμαντιάδη - Behcet είναι μία σπάνια πάθηση που χαρακτηρίζεται από φλεγμονή των αιμοφόρων αγγείων και των ιστών...

Οι επιστήμονες κάθε χρόνο.. ''πέφτουν με τα μούτρα'' στον αγώνα της αντιμετώπισης διαφόρων προβλημάτων υγείας, που ταλαιπωρούν πολλούς από...

Όποιος έχει πάει φαντάρος έχει περάσει από ιατρικά τεστ και γνωρίζει. Άλλος έχει μυωπία, άλλος έχει πλατυποδία, κάποιος πάσχει...

Ο χειμώνας έκανε δυναμικά την εμφάνιση του από τις πρώτες κιόλας ημέρες του 2013. Το τσουχτερό κρύο, η υγρασία...

Η παχυσαρκία είναι, τελικά, νόσος! Δεν διαφωνεί κανένας πλέον σ’ αυτήν την παρατήρηση, και μάλιστα οι...
Εννέα περιπτώσεις της νόσου των λεγεωναρίων στο Ηνωμένο Βασίλειο καταγράφηκαν και συνδέονται με το ταξίδι τους στην Κέρκυρα τον...